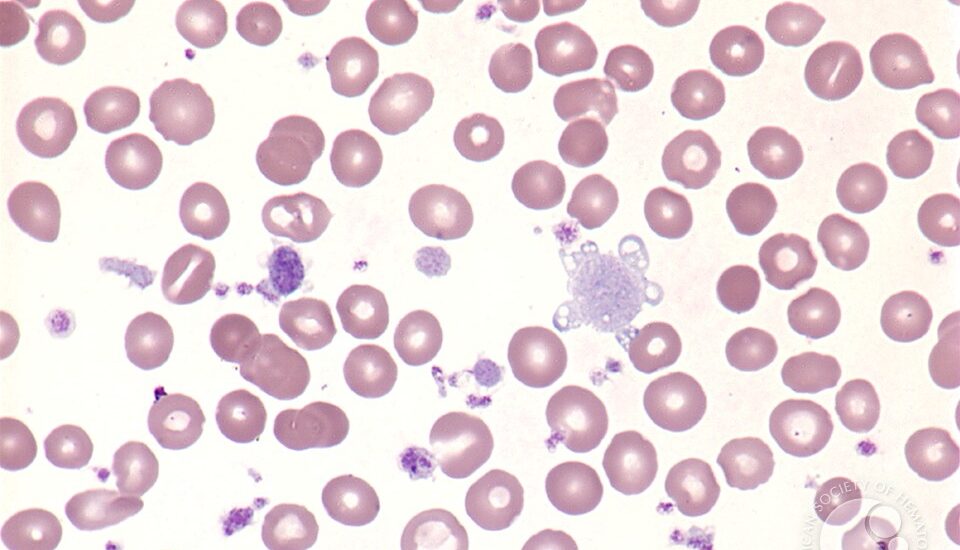

From 2023 to 2033, the global Myelofibrosis (MF) Treatment Market is expected to reach US$ 749.05 million, with a 5.5% CAGR. Globally, MF is becoming more common, and early detection is driving market growth. Furthermore, increased R&D activity by key players will create lucrative opportunities for Myelofibrosis (MF) Treatment market growth.
Myelofibrosis is distinguished by the presence of proteins known as Janus-associated kinases (JAKs). There will also be a discussion of emerging JAK inhibitor therapy and non-JAK inhibitor therapy, as well as the new challenge of switching from one JAK inhibitor therapy to another. Future therapies in this field are eagerly awaited, with new JAK inhibitors .
The treatment goals are usually to reduce splenomegaly and disease-related symptoms, to reduce complications like thrombosis and haemorrhaging, and, ideally, to slow disease progression. As the number of available agents for the treatment of myelofibrosis has increased over the last decade, therapeutic strategies have primarily focused on symptom management. According to a Future Market Insights report, global demand for myelofibrosis is expected to grow at a CAGR of 5.5% between 2023 and 2033, reaching a total of US$ 1,280 Million in 2033. (FMI). Sales increased significantly from 2018 to 2022, with a CAGR of 5.2%.
Take the first step towards enhanced performance and unmatched efficiency today! Request Sample Now :
https://www.futuremarketinsights.com/reports/sample/rep-gb-16296
The increase in awareness of Myelofibrosis (MF) Treatment and the increase in the number of patients are also expected to result in an increase.
Because of the complicated reimbursement associated with multiple patent expirations, the market for Myelofibrosis (MF) Treatment is expected to grow at a slow pace over the forecast period. Worldwide, myelofibrosis researchers are investigating strategies for treating and managing treatment side effects.
Ruxolitinib, the only approved therapy for MF and an oral JAK1/JAK2 inhibitor, is a potent oral JAK1/JAK2 inhibitor with clinical data, and agents in development are being studied. Patients with myelofibrosis have a number of treatment options available to them based on their symptoms and circumstances. Furthermore, the emergence of several diseases has resulted in the introduction of several drugs aimed at reducing blood volume and alleviating the symptoms of the various diseases.
Factors Driving the Global Myelofibrosis Treatments Market During the Pandemic Crisis, the development of new therapies received a significant boost.
The myelofibrosis treatment market is expected to grow as the prevalence of various genetic disorders rises and lifestyle choices improve. Revenue growth in the myelofibrosis treatment market is expected to be driven by an increase in the global number of smokers, which will support revenue growth. Furthermore, government investments in healthcare infrastructure, particularly in developing countries, are expected to increase, boosting revenue growth.
Unlock your investment potential today! Gain exclusive insights and expert analysis with our comprehensive analyst report :
https://www.futuremarketinsights.com/ask-question/rep-gb-16296
Globally, growing geriatric populations and new diagnostic tools are contributing to an increase in treatment options for myelofibrosis, which primarily affects people over the age of 50. The worsening of anaemia and splenomegaly. The increase in anaemic conditions and splenomegaly is also expected to result in a future increase in market conditions. Myelofibrosis is associated with thrombocythemia and polycythemia vera, in addition to exposure to industrial chemicals and radiation. As a result, these risk factors are becoming more prevalent among large segments of the population, driving market development.
Key Segments Profiled in the Myelofibrosis Market Industry Survey?
By Treatment Type:
- Targeted Therapy
- Chemotherapy
- Others
By Route of Administration:
- Oral
- Parenteral
- Others
By End User:
- Hospitals
- Homecare
- Specialty Clinics
- Others
By Distribution Channel:
- Hospital Pharmacy
- Online Pharmacy
- Retail Pharmacy
By Region:
- North America
- Latin America
- Europe
- South Asia
- East Asia
- Oceania
- Middle East & Africa
Insights Designed for You: Customize Your Exclusive Report Today:
https://www.futuremarketinsights.com/customization-available/rep-gb-16296
About Future Market Insights (FMI)
Future Market Insights, Inc. (ESOMAR certified, Stevie Award – recipient market research organization and a member of Greater New York Chamber of Commerce) provides in-depth insights into governing factors elevating the demand in the market. It discloses opportunities that will favor the market growth in various segments on the basis of Source, Application, Sales Channel and End Use over the next 10-years.
Contact Us:
Future Market Insights Inc.
Christiana Corporate, 200 Continental Drive,
Suite 401, Newark, Delaware – 19713, USA
T: +1-845-579-5705
For Sales Enquiries: sales@futuremarketinsights.com
Website: https://www.futuremarketinsights.com
LinkedIn| Twitter| Blogs | YouTube